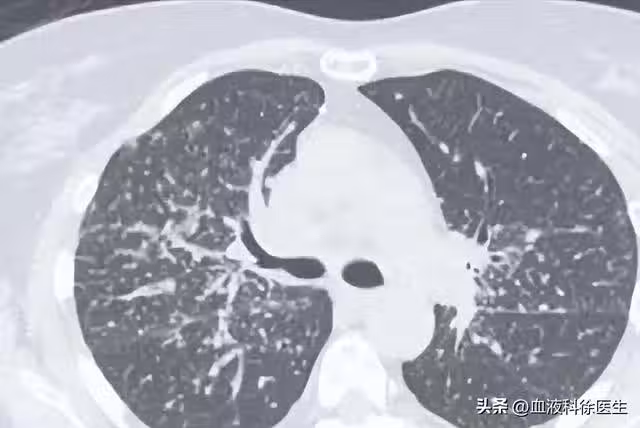

7/17
下一頁
55歲男子5月體檢發現肺結節,年底就肺癌晚期,醫生:警惕肺結節
7/17
這便可以解釋為什麼王叔叔身邊的許多同事也被發現有肺結節,因為肺結節的發病率在人群中確實不低,預計隨著吸菸、空氣污染及人口老齡化的影響,檢出率會進一步升高。
既然肺結節的檢出率這麼高,那麼究竟是什麼原因導致了早期肺癌或是肺結節的發生呢?
一、早期肺癌——肺結節的病因
既然肺結節的檢出率這麼高,那麼究竟是什麼原因導致了早期肺癌或是肺結節的發生呢?
一、早期肺癌——肺結節的病因
 幸山輪 • 29K次觀看
幸山輪 • 29K次觀看 幸山輪 • 840次觀看
幸山輪 • 840次觀看 喬峰傳 • 3K次觀看
喬峰傳 • 3K次觀看 呂純弘 • 1K次觀看
呂純弘 • 1K次觀看 李雅惠 • 350次觀看
李雅惠 • 350次觀看 幸山輪 • 640次觀看
幸山輪 • 640次觀看 幸山輪 • 270次觀看
幸山輪 • 270次觀看 幸山輪 • 640次觀看
幸山輪 • 640次觀看 老臘肉 • 950次觀看
老臘肉 • 950次觀看 李雅惠 • 190次觀看
李雅惠 • 190次觀看 李雅惠 • 180次觀看
李雅惠 • 180次觀看 呂純弘 • 550次觀看
呂純弘 • 550次觀看 李雅惠 • 180次觀看
李雅惠 • 180次觀看 喬峰傳 • 510次觀看
喬峰傳 • 510次觀看 老臘肉 • 4K次觀看
老臘肉 • 4K次觀看 喬峰傳 • 1K次觀看
喬峰傳 • 1K次觀看 奚芝厚 • 220次觀看
奚芝厚 • 220次觀看 許夢可 • 180次觀看
許夢可 • 180次觀看 舒黛葉 • 850次觀看
舒黛葉 • 850次觀看 喬峰傳 • 300次觀看
喬峰傳 • 300次觀看 幸山輪 • 130次觀看
幸山輪 • 130次觀看 喬峰傳 • 2K次觀看
喬峰傳 • 2K次觀看 幸山輪 • 290次觀看
幸山輪 • 290次觀看 呂純弘 • 5K次觀看
呂純弘 • 5K次觀看






















